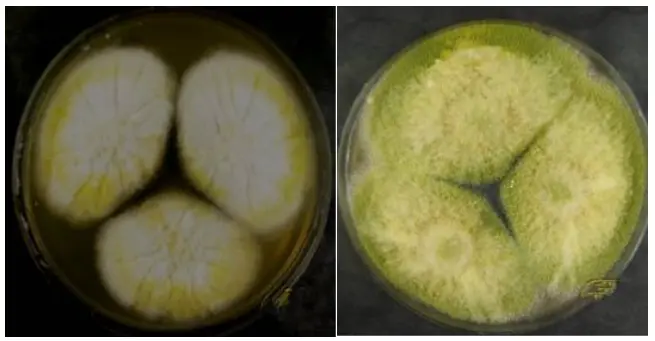
寄生曲霉
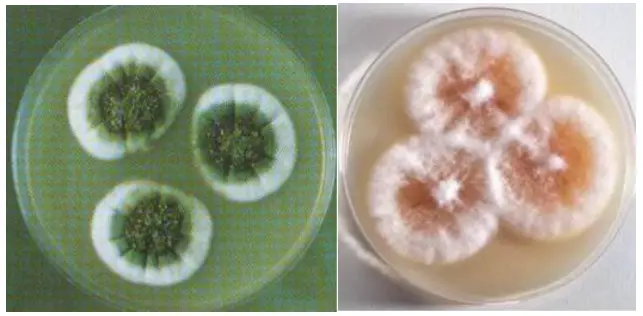
杂色曲霉
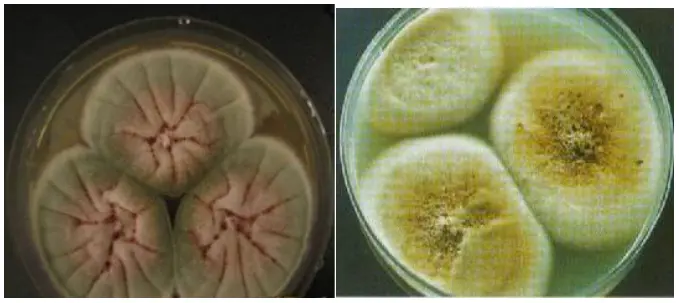
构巢曲霉
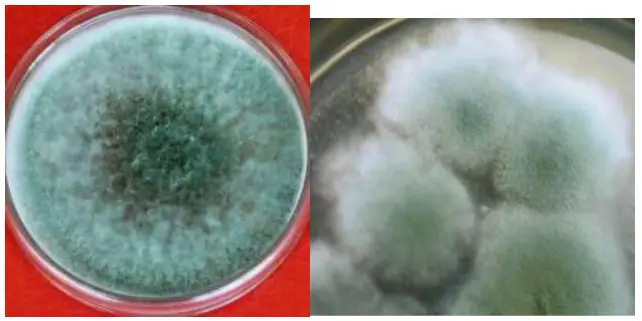
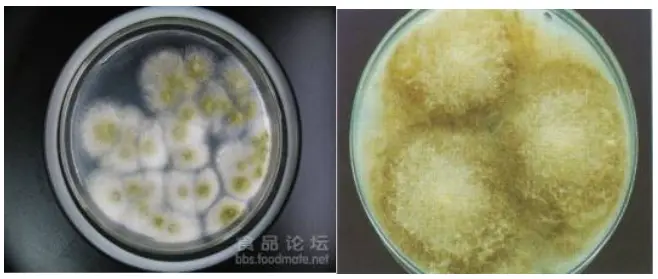
毛霉属

常见霉菌形态描述及典型菌落图片汇总!
发布时间:2022-09-27 浏览次数:20938
霉菌是微生物检测过程中常见的真菌种类,由于霉菌生理和繁殖的特殊性,很多霉菌都可以通过外观来基本判断种类。有经验的检验员看一眼平板上的霉菌的形态就差不多可以判断它的种类,很是令人佩服。你也想有这样的技能么?
我们在实验室检测中常见的霉菌有曲霉、青霉、木霉、毛霉、根霉等几大类,这几类霉菌在分类学上是不同的属,因此在外观形态上是有一定差别的,下面我们就分别介绍这几类霉菌的典型特征。
曲 霉 属
曲霉属包含的种类比较多,主要有黄曲霉、寄生曲霉、杂色曲霉、构巢曲霉等等,是一类可以产生生物毒素的菌属,其中黄曲霉和寄生曲霉产生的黄曲霉毒素更是臭名昭著。这类曲霉属的颜色多样,一般比较稳定,曲霉菌的菌丝是有隔菌丝,它的无性孢子是分生孢子,它的分生孢子很有特点,分生孢子梗末端膨大呈囊状称为顶囊,在顶囊上生出的放射状的瓶状结构,这叫做分生孢子小梗,小梗顶部就长了成串成串的小分生孢子,曲霉的孢子颜色各异,是区分曲霉种类的主要依据。
黄曲霉:在察氏培养基上菌落生长很快,直径可达3-4cm,一般初期为黄色,然后变为黄绿色,老后颜色变淡,平坦或有放射性沟纹,反面无色或带褐色。典型的黄曲霉如下图:

寄生曲霉:寄生曲霉一般培养8-10天是直径约2.5-4cm,平坦或带有放射性沟纹,幼时带黄色,老后呈暗绿色,反面奶油色至淡褐色。典型的寄生曲霉如图:
杂色曲霉:杂色曲霉在察氏培养基上生长比较受限制,一般是绒状、絮状或两者同时存在,颜色变化也比较多样,局部淡绿、灰绿、浅黄甚至是粉红,反面一般无色至浅黄色或玫瑰色,有的菌落有无色至紫红色的液滴。典型的杂色曲霉如图:
构巢曲霉:菌落一般生长较快,两周能达到5-6cm,绒状、绿色,部分菌系由于产生较多的闭囊壳而显黄褐色,反面一般为紫红色。典型构巢曲霉如图:
青 霉 属
青霉属分类比较复杂,包含的种也较多,但其形态特征均比较相似,因此肉眼观察很难辨别具体是什么菌种。但青霉属的形态特征还是比较明显的,青霉的营养菌丝体呈无色、单色或鲜明的颜色,具横隔,为埋伏型或部分埋伏型部分气生型,气生菌丝呈丝密毡状、松絮状或部分节省菌丝束。分生孢子梗由埋伏型或气生型菌丝生出,稍垂直于该菌丝,不像曲霉那样生有足细胞。典型的青霉属如下图:

上图从上至下、从左至右依次为金灰青霉、黄暗青霉、纯绿青霉、岛青霉
木 霉 属
木霉菌落开始时为白色,致密,圆形,向四周扩展,后从菌落中央产生绿色孢子,中央变成绿色。菌落周围有白色菌丝的生长带。最后整个菌落全部变成绿色。绿色木霉菌丝白色,纤细,宽度为1.5~2.4微米。产生分生孢子。分生孢子梗垂直对称分歧,分生孢子单生或簇生,圆形,绿色。绿色木霉菌落外观深绿或蓝绿色;康氏木霉菌落外观浅绿、黄绿或绿色。典型的木霉属如下图:
毛 霉 属
毛霉的菌丝体发达,菌落质地疏松,呈棉絮状,由许多分枝的菌丝构成。菌丝无隔膜,有多个细胞核。毛霉生长迅速,菌丝一般是白色,没有假根,属于单细胞真菌。典型的毛霉属如下图:
根 霉 属
事实上根霉属和毛霉属同属于毛霉目,因此两者形态比较相似。根霉属菌落疏松或稠密,最初呈白色,后变为灰褐色或黑褐色。菌丝匍匐爬行,无色。假根发达,分枝呈指状或根状,呈褐色。孢子刚出现时为黄色,成熟后变成黑色。根霉和毛霉主要区别在于,根霉有假根和匍匐菌丝,匍匐菌丝呈弧状,在培养基表面水平生长,而没有假根也没有匍匐菌丝,这一点是从外观上区分根霉和毛霉最显著的特征。典型的根霉如图所示:

其实,在我们的实验室里还会还有多种多样的霉菌,例如镰刀霉属、头孢霉属、交链孢霉属等等,事实上霉菌也并不是一个分类学定义,而仅仅是“发霉的真菌”这样一个俗称,所以即使现在最权威的分类学专家也无法完全界定霉菌分类的界限,我们通过霉菌的菌落外观也只是可以把霉菌区分到其中某一大类里,而无法界定到种的层次。虽然如此,但是这项技能还是很值得学习的,除了实用性,也增加了我们日常单调的检测工作的趣味性。
来源:食品微生物检测公众号,环凯小编转载分享!
提醒:文章、视频、图片等所有内容,仅用于学习交流,若有侵权内容及其他涉法内容,请及时联系删除或修改,特此声明!












